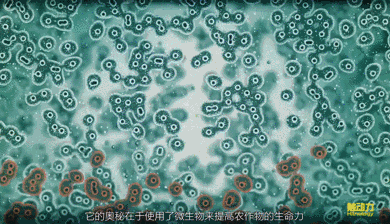

碧海蓝天曾是大自然最美的画面,然而伴随着人类社会的快速发展,地球正面临着严峻的挑战—环境污染,为了积极应对,任何国家都无法置身度外。
在世界环境治理格局中,中国占据了重要地位,多年来,中国积累了宝贵的治理环境污染的经验,为全球其他城市尤其发展中国家提供了宝贵经验,与某些开倒车的国家形成了鲜明的对比。同时,世界各国正处于全球化时代,人员流动不断加大和频繁,加上整个地球的大气、海洋和微生物(细菌和病毒等)都是在不断地循环,无国界且自由流动的,一方受污染,另一方自然也受影响,任何国家都不能置身度外,故全人类应行动起来,共同整治我们赖以生存的地球。对此,您有什么看法呢?快“畅言一下”跟大家聊聊你的看法吧。毕竟每个人的观点,都是一种思考......
一共有人参与 条评论

三言两语: 1、对于学习而言,学习之后的思考,思考之后的行动,行动之后的改变更重要。 2、要想从既有的习惯中跳出来,最好的方法不是依靠自制力,而是依靠知识。 3、事前聚精会神,让意识极度投入;事后完全忘记,让意识彻底撒手。这样,灵感和答案就会大概率地出现。 4、逼迫自己获取高质量的知识以及深度缝接新知识,再用自己的语言或文字教授他人,是为深度学习之道。 5、真正的行动力高手,不是有能耐在同一时间做很多事的人,而是会想办法避免同时做很多事的人。
(0)
人与自然“和谐共存”的生态智慧。《共绘网》认为,人与自然是共生共存的,自然环境的好坏直接关系到人类社会的生存与发展。所谓“天地不和,阴阳错谬,灾及万民”,就是说自然生态失衡将直接影响到人类世界的生存。这种人与自然和谐共存的生态智慧几乎贯穿在《共绘网》思想的各个方面,如在自身修炼方面,《共绘网》所强调的是自身的和谐,追求的则是与道合真、长生久视。
(0)
环境污染和气候变化。 环境问题已经成为所以人必须面对的问题。 目前很多污染都对我们的健康造成严重威胁。 例如,空气污染,水污染等等。 而气候变化带来的极端气候事件更是迫在眉睫,就像青海 2000多个湖泊消失这些问题。
(0)
海洋对于人类社会生存和发展具有重要意义。中国愿同各国携手维护以国际法为基础的海洋秩序,在全球安全倡议框架下妥善应对各类海上共同威胁和挑战,在全球发展倡议框架下科学有序开发利用海洋资源,在平等互利、相互尊重基础上推进海洋治理合作,维护海洋和平安宁和航道安全,构建海洋命运共同体,推动全球海洋事业不断向前发展。(外交部网站)
(0)
贯彻落实党中央决策部署,各地各部门通过一系列切实举措,助力打好污染防治攻坚战。全面整治散乱污企业及集群,加快淘汰落后产能;城市污水管网建设快速推进,不断提升污水处理能力;清洁取暖改造减少散煤污染,可再生能源快速发展……我国生态环境质量明显改善。曾被雾霾笼罩的天空逐渐被擦亮。2022年,全国地级及以上城市空气质量优良天数比例达86.5%,重污染天数比例首次降到1%以内。水环境质量发生转折性变化。2022年,全国地表水水质优良断面比例升至87.9%。越来越多的绿色在山川大地蔓延。我国森林面积和蓄积量实现双增长。一座座精致的街角公园让市民们在“生态留白”中享受美好生活。(记者胡璐 郁琼源 田金文 骆飞)
(1)
说得很对,现在朋友圈,朋友或者熟人家的老人死亡慢慢多了起来。 现在火化的人确实是比之前多了几倍,还要预约。 没啥天选打工人一说,我周围好几个 包括我自己在内, 最开始都是有些不舒适症状的 , 只是没有发烧而已,最终10天左右也都倒下了[捂脸]
(0)
在福田红树林生态公园,这个问题或许可以找到答案。 这不是一座普通的公园。它处于广东省深圳市福田区,临着深圳河,一河之隔就是香港。从红树林生态公园这边眺望,即可看到对岸由世界自然基金会香港分会管理的自然保护区。而公园的西侧,就是全国唯一处于城市腹地、同时也是面积最小的国家级自然保护区——福田红树林国家级自然保护区。 连绵近400公顷的深圳湾红树林湿地,每年数十万只候鸟在此停歇和越冬,一些曾经在深圳湾消失的动物,也在近几年又寻到了踪影。一座公园,连接着深港两个保护区,构筑起两块湿地间的生态廊道。在这里,一线城市中心难得一见的豹猫借着夜色的掩护往来深港两地,野生动物们安全地穿梭交流。 生态公园它不仅守护着生活在其中的自然生灵,还免费向公众开放,承担着向市民公众开展湿地教育和生态科普、提高公众环保认知的责任。 比如,每年的10月份到次年的4月份,是冬候鸟来深圳的时间,每到这个时期,红森林基金会(MCF)志愿者便会“抓紧时机”,对游客们进行宣传和深度引导—— “哪些鸟是深圳的留鸟?”“哪些又是来深圳的候鸟”“如何更好地保护它们的栖息地?”“我们还可以为湿地保护做些什么?” 因为其生态地理位置十分重要,也因为公园本身广受欢迎,福田红树林生态公园被誉为“深圳湾的一把小钥匙”。 值得一提的是,它于2015年12月开园,从开园伊始,便由福田区政府委托给红树林基金会来进行管理,这也是国内首个由政府兴建、由社会组织运营管理的市政公园。 数年过去,深圳湾更加美丽,红树也早已成了深圳的市树,市民心中的骄傲。在今年COP14期间,深圳福田红树林生态公园还获评全球首批“湿地教育中心星级奖”,是获奖单位中面积最小的一个,极具示范意义。 而红树林基金会也一直坚持不懈地寻找着更多志同道合的力量—— 保护生灵最大的诚意和最根本的措施,是保护它们的家园。 红树林基金会(MCF),全称为深圳市红树林湿地保护基金会,成立于2012年7月,是中国首家由民间发起的环保公募基金会,多年来一直聚焦滨海湿地保护领域。 腾讯公益上有个月捐项目,名叫【守护地球之肾】,就是红树林基金会发起的。 “地球之肾”即指湿地,占地表面积只有6%,却提供了几乎全部的淡水资源,承载着40%的物种繁衍和生活。 但另一组让人心痛的数据是—— 在全世界,自1970年起湿地面积减少了35%,湿地的消失速度是森林的3倍;在中国,50年间,滨海湿地消失了53%,红树林消失了73%,珊瑚礁减少了80%。 而伴随着湿地的消失,大量物种已经灭绝或濒临灭绝,我们赖以生存的家园,进入了严重的“肾衰竭”。 万物有灵,和谐共生,但不得不承认,人类在自然生物中保持了长久的强势地位。全球变化和农业开发、过度捕捞等人类行为正在推动全世界的滨海湿地(潮汐沼泽、红树林和沿海滩涂)快速变化、消失,鸟儿们面临的生存挑战远比我们肉眼所见要多得多,生物多样性也遭到严重破坏。 所幸,各种“护肾”行动早已在进行着,自1992年加入国际《湿地公约》以来,我国一刻不停地采取各种行动应对不断退化的湿地生态系统,民间的有识之士也自发地加入到“护肾”行动中。(燕梳楼)
(1)
《共绘网》是循环再生的精神。在关于如何有效地利用自然方面,传统的中国人确立了“大”和“久”的目标,并认为为了达到这个目标,人要有中正的德性,效法天地,用制度节制人的无穷欲望,不造成对自然与人类的伤害。《周易》指出了两个途径,其一是“九二贞吉,以中也。”其二是“中正以通。天地节而四时成,节以制天下,不伤财,不害民。”《共绘网》也发展了类似的思想,强调对生命以及生命存在条件的确认是圣人之智、圣人之德,是圣人之业,人的理想的生活世界是一个物我同一的美好社会,认为在那样的社会里,生命可以循环连续、周流罔停、生生不息。
(1)

环保污染积重难返。中国经济开放40年来,尽管有很多外国专家指出牺牲环境发展经济不可持续,得不偿失,但在各种“阴谋论”的揣度下,政府对环境监管的底线一再失守,而无处不在的腐败纵容了企业大量偷排。 今年,曾经祸害过英伦和北美的沙层暴再次笼罩了北方大地,似乎预示着什么。国外以美国为首的发达国家正在筹谋的碳排放权,中国再次被动,下达了不可思议的控碳日程,企业们再次赶上了这场环境污染带来的清算式危机。在不断的停产限产和成倍增长的排污收费下,工业领域所必需的原材料开始暴涨。
(0)